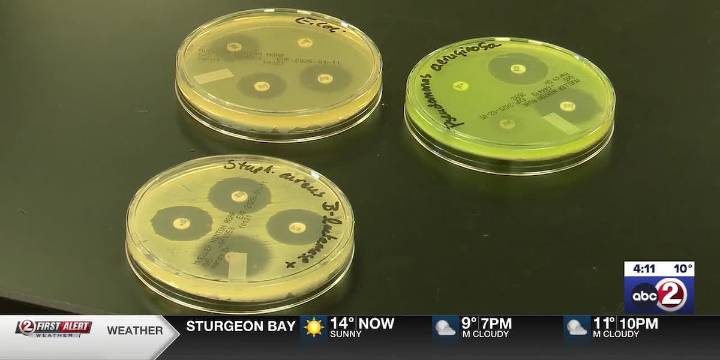
Tiny Earth hopes to combat antibiotic resistant bacteria

GREEN BAY, Wis. (WBAY) - Students at Northeast Wisconsin Technical Collage WTC are looking for ways to fight antibiotic resistant bacteria as part of an eight-year project with Tiny Earth, a worldwide initiative.
“People are getting infections that are not curable by any antibiotics,” said Angelo Kolokithas, Director of Biology Program at NWTC.
A growing number of infections, like pneumonia and strep throat, are becoming harder to treat with antibiotics. Misuse is a contributing factor.
The Director of Biology Angelo Kolokithas at Northeast Wisconsin Technical College says the biotech and pharmaceutical industries are not looking for many of these antibiotics now because of the expense.
Tiny Earth students are helping while spreading awareness of the antibiotic resistance crisis worldw

 WMTV NBC15
WMTV NBC15
America News
America News Raw Story
Raw Story CNN Health
CNN Health NBC News
NBC News Cleveland 19 News
Cleveland 19 News The Newport Daily News
The Newport Daily News CNN
CNN